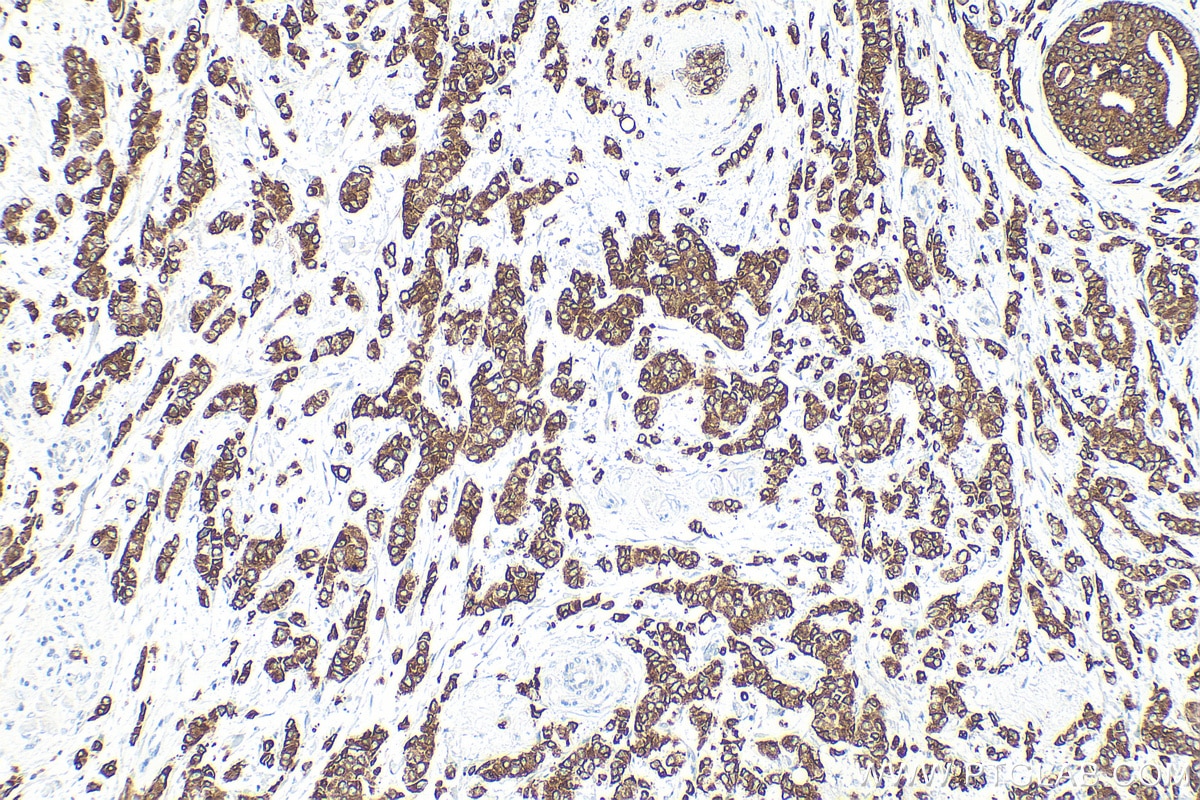
Immunohistochemistry (IHC) staining of human breast cancer tissue using Cytokeratin 19 Polyclonal antibody (14965-1-AP)
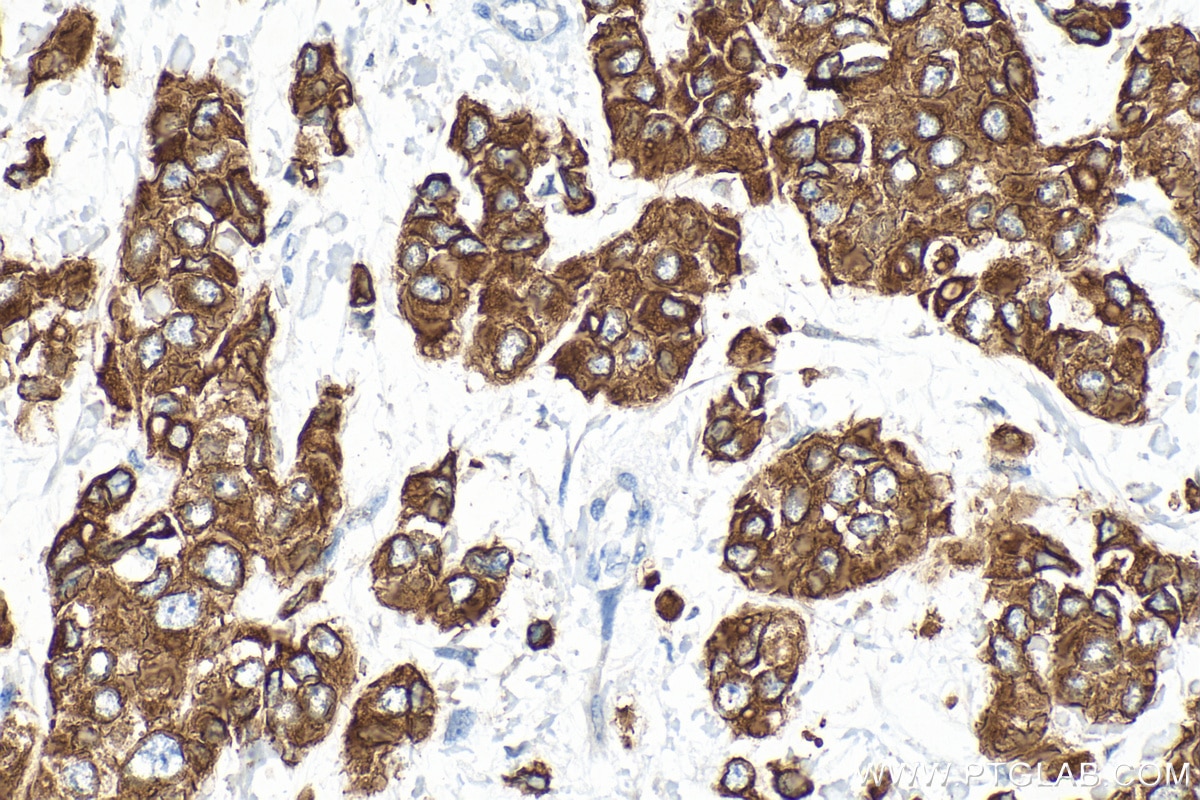
Immunohistochemistry (IHC) staining of human breast cancer tissue using Cytokeratin 19 Polyclonal antibody (14965-1-AP)
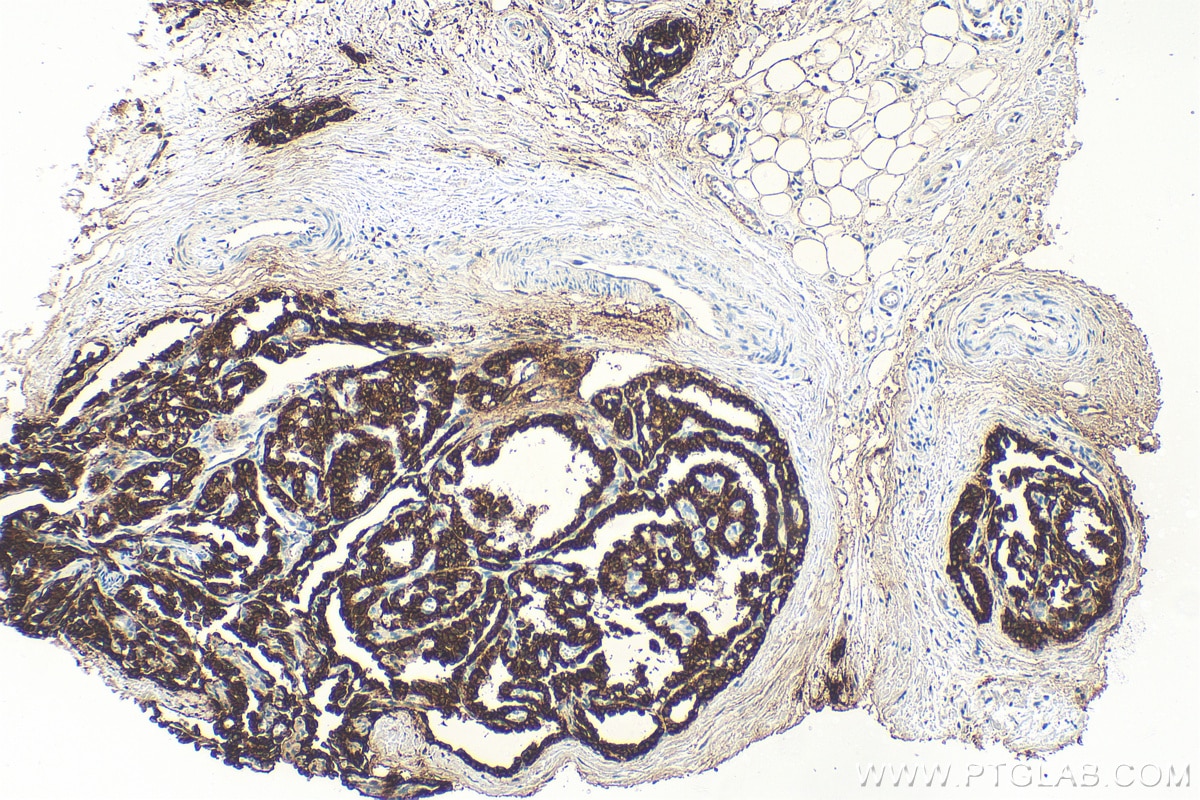
Immunohistochemistry (IHC) staining of human thyroid cancer tissue using Cytokeratin 19 Polyclonal antibody (14965-1-AP)
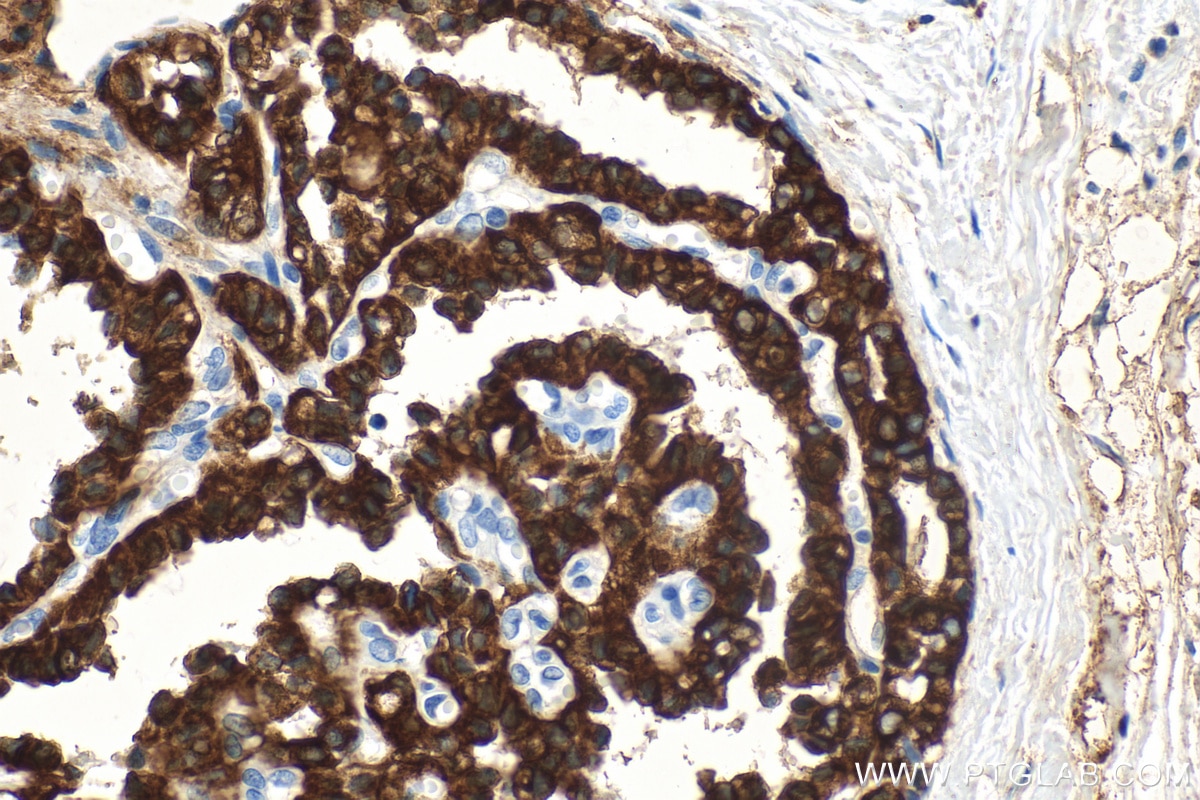
Immunohistochemistry (IHC) staining of human thyroid cancer tissue using Cytokeratin 19 Polyclonal antibody (14965-1-AP)
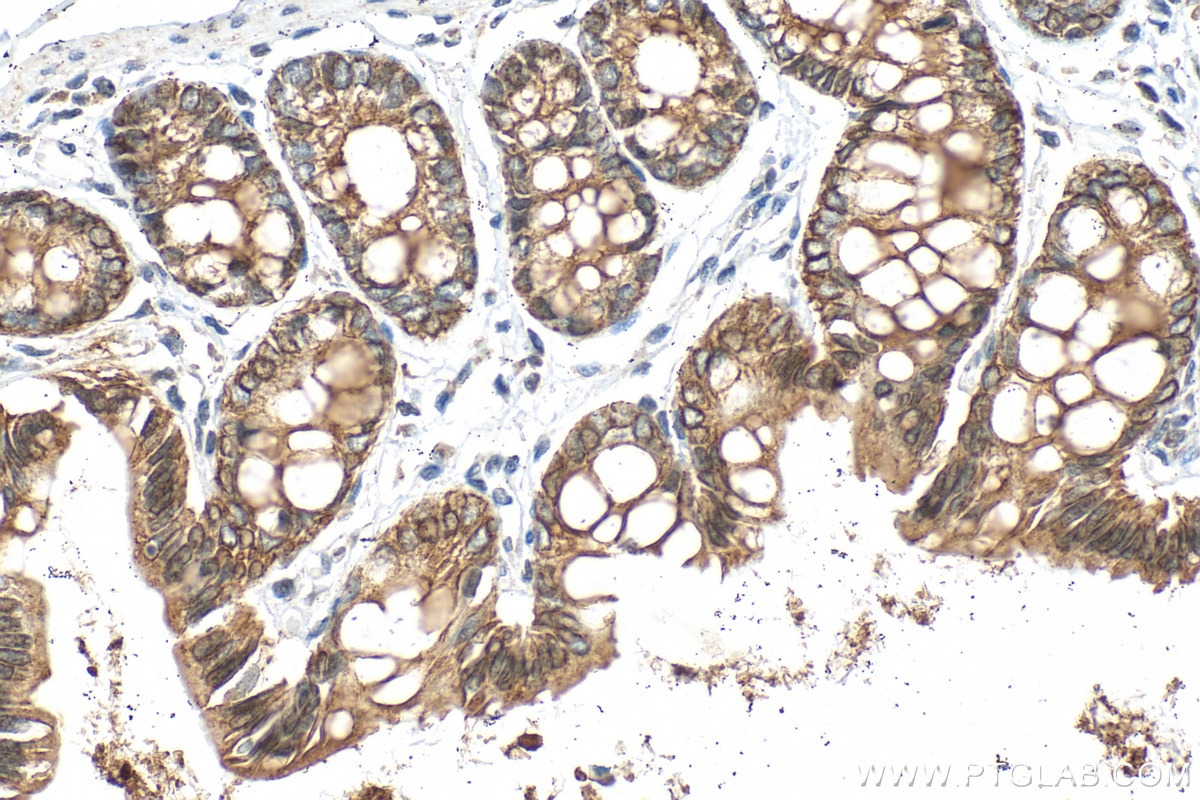
Immunohistochemistry (IHC) staining of rat colon tissue using Cytokeratin 19 Polyclonal antibody (14965-1-AP)
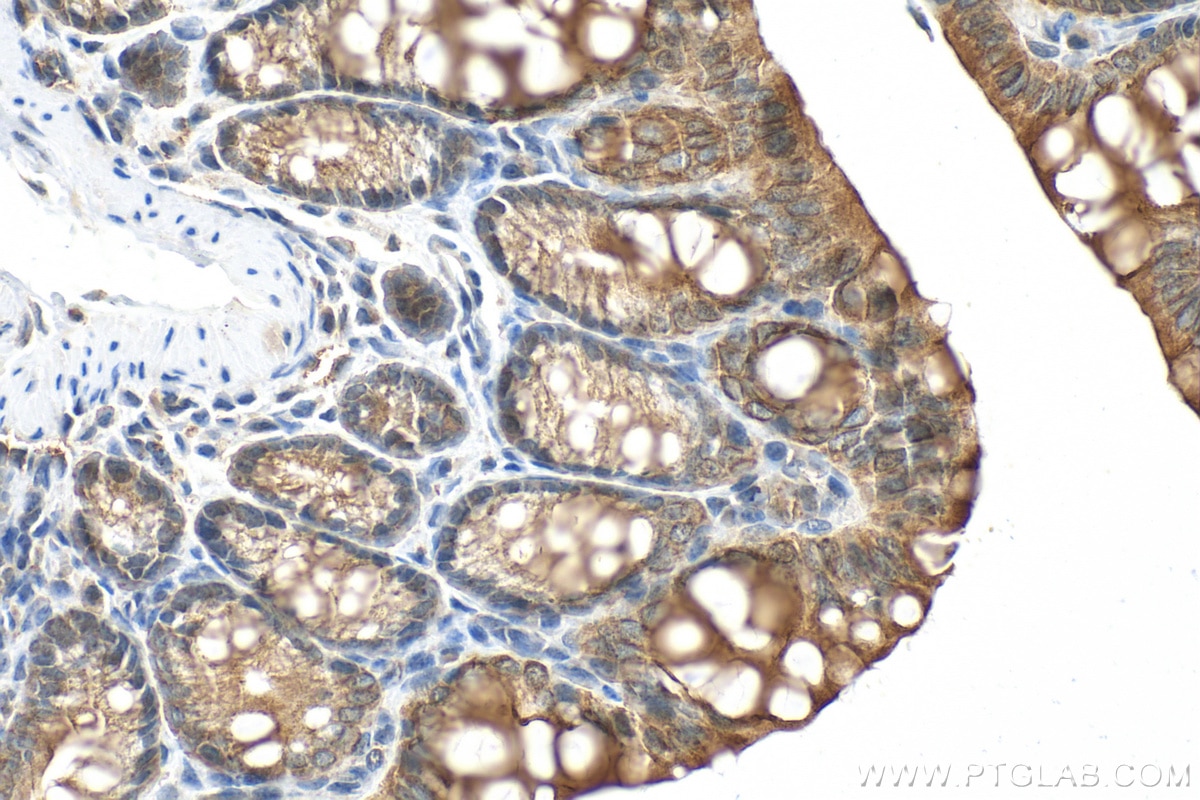
Immunohistochemistry (IHC) staining of mouse colon tissue using Cytokeratin 19 Polyclonal antibody (14965-1-AP)

Tested Applications
| Positive WB detected in | HepG2 cells, BxPC-3 cells, HeLa cells |
| Positive IHC detected in | human colon tissue, human breast cancer tissue, human brown disease, human cervical cancer tissue, human liver cancer tissue, human lung cancer tissue, human thyroid cancer tissue, mouse colon tissue, rat colon tissue Note: suggested antigen retrieval with TE buffer pH 9.0; (*) Alternatively, antigen retrieval may be performed with citrate buffer pH 6.0 |
| Positive IF-Fro detected in | mouse liver tissue |
| Positive IF/ICC detected in | HeLa cells, A431 cells |
| Positive FC (Intra) detected in | MCF-7 cells |
Recommended dilution
| Application | Dilution |
|---|---|
| Western Blot (WB) | WB : 1:5000-1:50000 |
| Immunohistochemistry (IHC) | IHC : 1:150-1:600 |
| Immunofluorescence (IF)-FRO | IF-FRO : 1:50-1:500 |
| Immunofluorescence (IF)/ICC | IF/ICC : 1:200-1:800 |
| Flow Cytometry (FC) (INTRA) | FC (INTRA) : 0.40 ug per 10^6 cells in a 100 µl suspension |
| It is recommended that this reagent should be titrated in each testing system to obtain optimal results. | |
| Sample-dependent, Check data in validation data gallery. | |
Published Applications
| KD/KO | See 1 publications below |
| WB | See 3 publications below |
| IHC | See 8 publications below |
| IF | See 9 publications below |
Product Information
14965-1-AP targets Cytokeratin 19 in WB, IHC, IF/ICC, IF-Fro, ELISA applications and shows reactivity with human, mouse, rat samples.
| Tested Reactivity | human, mouse, rat |
| Cited Reactivity | human, mouse, rat, monkey |
| Host / Isotype | Rabbit / IgG |
| Class | Polyclonal |
| Type | Antibody |
| Immunogen |
CatNo: Ag6830 Product name: Recombinant human KRT19 protein Source: e coli.-derived, PGEX-4T Tag: GST Domain: 1-400 aa of BC002539 Sequence: MTSYSYRQSSATSSFGGLGGGSVRFGPGVAFRAPSIHGGSGGRGVSVSSARFVSSSSSGGYGGGYGGVLTASDGLLAGNEKLTMQNLNDRLASYLDKVRALEAANGELEVKIRDWYQKQGPGPSRDYSHYYTTIQDLRDKILGATIENSRIVLQIDNARLAADDFRTKFETEQALRMSVEADINGLRRVLDELTLARTDLEMQIEGLKEELAYLKKNHEEEISTLRGQVGGQVSVEVDSAPGTDLAKILSDMRSQYEVMAEQNRKDAEAWFTSRTEELNREVAGHTEQLQMSRSEVTDLRRTLQGLEIELQSQLSMKAALEDTLAETEARFGAQLAHIQALISGIEAQLGDVRADSERQNQEYQRLMDIKSRLEQEIATYRSLLEGQEDHYNNLSASKVL Predict reactive species |
| Full Name | keratin 19 |
| Calculated Molecular Weight | 44 kDa |
| Observed Molecular Weight | 40 kDa, 46 kDa |
| GenBank Accession Number | BC002539 |
| Gene Symbol | Cytokeratin 19 |
| Gene ID (NCBI) | 3880 |
| RRID | AB_2133324 |
| Conjugate | Unconjugated |
| Form | Liquid |
| Purification Method | Antigen affinity purification |
| UNIPROT ID | P08727 |
| Storage Buffer | PBS with 0.02% sodium azide and 50% glycerol, pH 7.3. |
| Storage Conditions | Store at -20°C. Stable for one year after shipment. Aliquoting is unnecessary for -20oC storage. 20ul sizes contain 0.1% BSA. |
Background Information
Cytokeratin 19 (CK19 or KRT19) is a type I (acidic) cytokeratin. It is an intermediate filament protein providing structural rigidity and multipurpose scaffolds in epithelial cells. CK19 is often overexpressed in various cancers (e.g., hepatocellular carcinoma [HCC], pancreatic adenocarcinoma, lung cancer) and serves as a biomarker for hepatic progenitor cells (HPCs) associated with poor prognosis in HCC patients . Additionally, CK19 expression is common in pancreatic and gastrointestinal adenocarcinomasand has been studied as a potential diagnostic and prognostic marker for pancreatic neuroendocrine tumors (PNETs), where positive CK19 expression correlates with poor prognosis. Serum CK19 fragments (e.g., CYFRA 21-1, CK19-2G2) have been investigated as tumor markers for lung and breast cancer, with preoperative levels associated with metastasis and survival. This antibody, generated against full length KRT19 protein, also recognizes KRT17, another type I keratin homologous to KRT19.
Protocols
| Product Specific Protocols | |
|---|---|
| FC protocol for Cytokeratin 19 antibody 14965-1-AP | Download protocol |
| IF protocol for Cytokeratin 19 antibody 14965-1-AP | Download protocol |
| IHC protocol for Cytokeratin 19 antibody 14965-1-AP | Download protocol |
| WB protocol for Cytokeratin 19 antibody 14965-1-AP | Download protocol |
| Standard Protocols | |
|---|---|
| Click here to view our Standard Protocols |
Publications
| Species | Application | Title |
|---|---|---|
Gastroenterology ECM1 Prevents Activation of Transforming Growth Factor β, Hepatic Stellate Cells, and Fibrogenesis in Mice. | ||
Int J Biol Sci Hepatobiliary organoids differentiated from hiPSCs relieve cholestasis-induced liver fibrosis in nonhuman primates | ||
Cell Rep In Vivo Functional Platform Targeting Patient-Derived Xenografts Identifies WDR5-Myc Association as a Critical Determinant of Pancreatic Cancer. | ||
Arch Toxicol Galunisertib modifies the liver fibrotic composition in the Abcb4Ko mouse model. | ||
Mol Cancer Res METTL3-mediated m6A modification regulates the polycomb repressive complex 1 (PRC1) components BMI1 and RNF2 in hepatocellular carcinoma cells |
Reviews
The reviews below have been submitted by verified Proteintech customers who received an incentive for providing their feedback.
FH Sai Sindhura (Verified Customer) (01-08-2026) | CYTOKERATIN works very good
|
FH Mounika (Verified Customer) (01-08-2026) | Wonderful antibodies, easy to use, Happy!
|